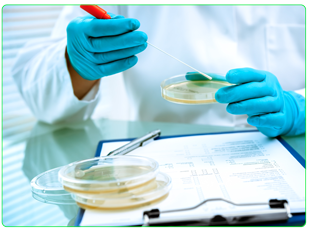
Biologie de la femme enceinte chez SCIENTILABO

Qu'est ce que La microbiologie alimentaire ?
La microbiologie alimentaire est l'étude des micro-organismes qui colonisent, forment ou contaminent les aliments. Si l'étude des micro-organismes à l'origine de la détérioration des aliments est une composante essentielle de cette branche de la science agro-alimentaire, les « bonnes » bactéries, telles que les probiotiques, prennent désormais une importance croissante.
En effet, les micro-organismes sont absolument essentiels pour la production d'aliments tels que le fromage, le yaourt, le pain, la bière, le vin et d'autres aliments fermentés.
Pourquoi Nous Choisir?
Pour garantir la qualité des résultats, nous avons plus de 34 ans d'expérience , gage important de qualité et de régularité. Dans ce cadre, des experts techniques indépendants vérifient régulièrement le respect des conditions d'exploitation et de nos engagements qualité établis. De plus, des contrôles sont organisés tout au long de l'analyse : test de bactéries de référence, contrôle de l'environnement stérile, comparaison avec d'autres laboratoires, etc.
En outre, la traçabilité des opérations est garantie en permanence : opérateur, lot de réactifs, temps et température d'incubation etc...